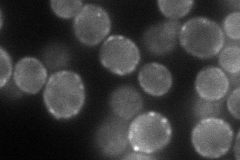
YDR150W
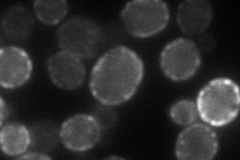
YDR150W
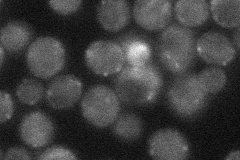
YDR150W
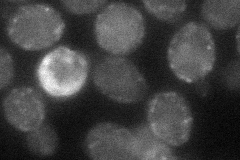
YDR150W
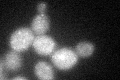
YDR150W

View description
Protein required for nuclear migration, localizes to the mother cell cortex and the bud tip; may mediate interactions of dynein and cytoplasmic microtubules with the cell cortex
Localization:
Intensity:
Fold change:
Significance:
-
C’ GFP library in SD

punctate32.76 -
N' NOP1pr-GFP in SD
cytosol,cell periphery,punctate72.95 -
N' TEF2pr-mCherry in SD
cell periphery,punctate52.6799 -
N' NATIVEpr-GFP in SD
punctate29.8376 -
N' TEF2pr-VC and Cyto-VN in SD
cell periphery,punctate40.6081 -
C’ GFP library in SD+DTT
punctate32.911No -
C’ GFP library in SD+H2O2

punctate36.481.11No -
C’ GFP library in Starvation Media

punctate24.920.76No -
C’ GFP library on the background of Pup2-DaMP

N/A -
C’ GFP library on the background of CCT mutant

N/A0N/AYes
